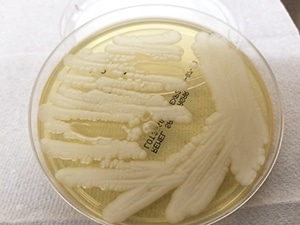

Anne Paxton
March 2020—While developing into a global health emergency that has killed thousands, the outbreak of the SARS-CoV-2 coronavirus identified in China riveted the public and raised awareness of infectious diseases and their perils.
But despite its ability to empty city streets in China and devastate communities, from a medical standpoint SARS-CoV-2 has an advantage. It rapidly gained worldwide attention, spurring the development of rapid diagnostic methods and potential treatment modalities. In contrast, the yeast Candida auris, a different emerging species of pathogen that is well below the public’s radar, has not only the potential for severe harm and a pattern of spreading easily in the hospital, but also the danger of being difficult to identify and treat.
C. auris, first isolated in 2009, does not pose anywhere near the hazard that SARS-CoV-2 does, but the Centers for Disease Control and Prevention says that C. auris presents a serious global health threat. Candida is one of the leading causes of hospital-acquired bloodstream infections and C. auris presents unique challenges, says Romney Humphries, PhD, D(ABMM), chief scientific officer, Accelerate Diagnostics, Tucson, Ariz., and a member of the CAP Microbiology Committee. “If we don’t keep an eye on it, it does have the possibility to expand very rapidly and be very problematic for some of our sickest patients,” she warns. A new article by Dr. Humphries, D. Jane Hata, PhD, D(ABMM), and Shawn Lockhart, PhD, D(ABMM), in Archives of Pathology & Laboratory Medicine details the distinct challenges that C. auris poses for laboratory diagnostics and for infection prevention and treatment (2020;144[1]:107–114).
C. auris is the first yeast to cause an infection that is both multidrug resistant and frequently misidentified by the forms of testing available in most clinical microbiology laboratories. “If you don’t have a good identification method, you don’t really know what your prevalence is,” says Dr. Hata, director of microbiology at Mayo Clinic, Jacksonville, Fla., and a former member of the CAP Microbiology Committee. However, with C. auris having become a nationally reportable condition in 2018, the information on its prevalence will likely improve in the years ahead.

“From a global public health perspective,” Dr. Humphries says, “people are worried about C. auris because it has such a propensity to mutate and become resistant to all the different classes of antifungal.” About 40 percent of C. auris isolates will be resistant to two or more drug classes, and 10 percent will be resistant to all antifungal drugs. C. auris is not more pathogenic than other drug-resistant pathogens, she adds, but it is associated with health care exposure, and “the type of patients who typically become infected with C. auris are already very sick.”
“There’s a real desire to be able to identify this and understand the epidemiology and track it,” she says, “just as we do with multidrug resistant bacteria.” Accurate laboratory identification is a key part of that. Preventing the spread of C. auris in the hospital can be accomplished through infection control activities, Dr. Humphries says, “but that can only be done if you know who has the infection.”
While it is still rare in the U.S.—as of June 2019, 725 confirmed and 30 probable cases of C. auris infection had been reported, mostly in hospitals and nursing homes in New York City, New Jersey, and Chicago—multiple strains of C. auris called clades have emerged independently in various parts of the world since the species was first identified. It is unprecedented to observe the simultaneous rapid worldwide emergence of a newly identified Candida species, Drs. Humphries and Hata say.
“This is an extremely interesting organism because prior to 2009, it had never been reported,” Dr. Hata says. “One of the valuable things when we investigated the emergence of C. auris was that we had large collections of Candida isolates from all over the world going back to 2001. We looked at those older isolates using various genomic methods to see if we could detect it, and no strains of C. auris were detected in these large culture collections before 2009. So this speaks to the fact that we have a newly emerging Candida species.”
It’s an emergence that has undermined two long-standing assumptions about Candida infections: that standard infection control practices can ward off outbreaks and that Candida can be effectively treated because most Candida isolates are susceptible to available antifungal agents. C. auris is resistant to agents commonly used to treat Candida infection such as fluconazole. “We also see resistance, in some cases, to our echinocandins like caspofungin which target the fungal cell wall, as well as our drug of last defense: amphotericin B. And C. auris seems to be developing more resistance the more we see of it, which is a huge concern,” Dr. Hata adds.

“C. auris is also very unusual in exhibiting environmental persistence. These yeast can survive on a dry surface for seven to 14 days and be recovered and become viable again. Some studies have reported they can be environmentally resistant but recoverable after one month, which is extremely unusual for any yeast species. So C. auris presents special issues when it comes to decontamination of surfaces and cleaning of patient rooms, as well as handling in the laboratory.”
Adding to the complications, people may become colonized with C. auris on their skin but not exhibit symptoms of disease, and accurate identification of colonizing organisms can be a challenge for the laboratory, Dr. Hata says. And although the CDC currently recommends that health care facilities place patients with C. auris colonization or infection in single rooms, “there’s a big infection control problem because patients aren’t ill, so they may not be placed under the appropriate isolation precautions to prevent C. auris from spreading throughout a hospital unit.”
[dropcap]A[/dropcap]s explained in the Archives article, C. auris cannot be identified by morphology alone, and commercially available phenotypic methods fall short in accurately identifying it. Automated and nonautomated biochemical methods have performance issues, and overlapping biochemical profiles and limitations in identification databases can cause a low confidence result, misidentification as another Candida species such as C. sake or C. famata, or genus-level identification (Candida species) only.

(Courtesy: Diana M. Meza Villegas, MS, SM(ASCP)CM, and Miranda E. Diaz, BS, SM(ASCP)CM, Mayo Clinic Florida microbiology laboratory.)
“Most clinical laboratories still use a combination of macroscopic and microscopic morphology along with biochemical testing to identify Candida to a species level,” Dr. Hata says. “These techniques are not acceptable to identify C. auris accurately. The problem with this organism is that it can look like small yeast. Sometimes they are single cells, sometimes they cluster together. C. auris generally does not form pseudohyphae like most other Candida species, so it looks very different from the others when you are looking at it under a microscope.”
The biochemical profile of C. auris can also overlap with other Candida species, and the identification databases used by the commercial biochemical systems often do not contain C. auris, Dr. Hata adds. “There are some exceptions to this rule but, generally speaking, morphologic and biochemical methods should not be used to identify C. auris. The only good method we have, other than doing whole genome sequencing or conventional sequencing, which is considered the gold standard method, is that of MALDI-TOF.”
With a MALDI-TOF—either Bruker MALDI Biotyper or Vitek MS by BioMérieux—labs can generally identify C. auris, provided they have the updated databases, Dr. Humphries says. “That’s not so much of a challenge now as it was at the beginning of this emergence.” In 2018, both MALDI-TOF systems received FDA approval to include C. auris in their identification database.
Turnaround time can vary but the MALDI-TOF procedure itself is fast, Dr. Hata says. “Once you have a pure isolate available to run on the MALDI, the actual time on the instrument is very short. In our hands it’s less than an hour to do.” The main issue with MALDI-TOF is that although the cost of the test is quite low, the cost of the instrumentation is high. Says Dr. Humphries, “If the lab is not using a MALDI-TOF, it would need to send the sample to a reference lab or to a public health department lab to have confirmatory testing done on it.”
Courtesy: Diana M. Meza Villegas, MS, SM(ASCP)CM, and Miranda E. Diaz, BS, SM(ASCP)CM, Mayo Clinic Florida microbiology laboratory.
Laboratories using FDA-approved versions of MALDI-TOF database libraries should be able to accurately identify C. auris. Using a manufacturer’s protocols, labs could also create their own custom research-use-only database library. The CDC, in collaboration with Bruker, offers an online tool that provides accurate classification of C. auris to the species level (www.cdc.gov/microbenet/index.html). Qualified laboratories can also obtain well-characterized isolates of C. auris from the CDC and FDA Antibiotic Resistance Isolate Bank to assist with verification or validation of FDA-approved or RUO organism identification databases (www.cdc.gov/drugresistance/resistance-bank/index.html).
“Developing our own database is what my laboratory did because we needed a method to be able to identify C. auris, but we didn’t have the FDA approval for C. auris yet,” says Dr. Hata.
Dr. Humphries notes the CDC’s online tools have practical tips on identification and how to interpret antifungal susceptibility test results. “There are no clinical breakpoints for this organism,” she says, “meaning there’s no official definition of what MIC [minimum inhibitory concentration] is susceptible and what MIC is resistant, but the CDC has guidance on an interim approach for handling that.”
Molecular sequencing can provide definitive identification of C. auris, but the financial investment needed and the technical requirements for sequencing tend to preclude routine use. “It is just the large academic medical centers or reference laboratories that do this, and not all of them have the bandwidth to routinely evaluate their sequencing databases for new fungal agents,” Dr. Humphries says.
C. auris is starting to be added to rapid multiplexed molecular testing systems. GenMark Diagnostics and BioFire Diagnostics have added C. auris to their blood culture panels—the ePlex BCID-FP (FDA cleared) and the BCID2 panel (pending FDA clearance), respectively. “However, there are no FDA-cleared screening tests at this point for C. auris, which makes identification of colonized patients challenging.”
At least one other technology is commercially available to test for Candida auris: magnetic resonance. The T2Cauris Panel by T2 Biosystems is a research-use-only panel that performs rapid detection of C. auris, C. duobushaemulonii, and C. haemulonii from blood, skin, and environmental swab samples. But the instrumentation is costly, Dr. Hata says, and applicability to identify a wide variety of Candida (including C. auris) is limited. “A lot of laboratories have to balance the cost of a given instrument with the number of different tests they can perform in order to make a good economic case for it.”
But hospitals do need better preparation for the C. auris pathogen, Dr. Humphries says, and testing is an obstacle. “If we were to wind up in an outbreak situation, hospitals don’t have good surveillance for patients who might be colonized but not necessarily infected. We don’t have a good way to screen for that right now, or to do a prevalence study. That’s one of the bigger challenges we’re facing.”
Says Dr. Hata: “Tests are very slow to come through the FDA approval process and we’d like to see more. It’s also important to have tests that are amenable to all levels of laboratories, not just reference laboratories, not just large commercial laboratories, but local, smaller laboratories. We have to have tests that are accurate, affordable, and can be performed in smaller labs.”
Meanwhile, the emergence of C. auris underlines the need for laboratories to make sure they don’t ignore yeast, Dr. Humphries stresses. “If you look at the CAP [Surveys] data, far more labs perform antibacterial susceptibility testing than do antifungal testing. I think that’s something that will change over time, but labs need to be aware that antifungal testing is an important patient care function and they should keep up with what’s going on in the literature.”
Anne Paxton is a writer and attorney in Seattle.